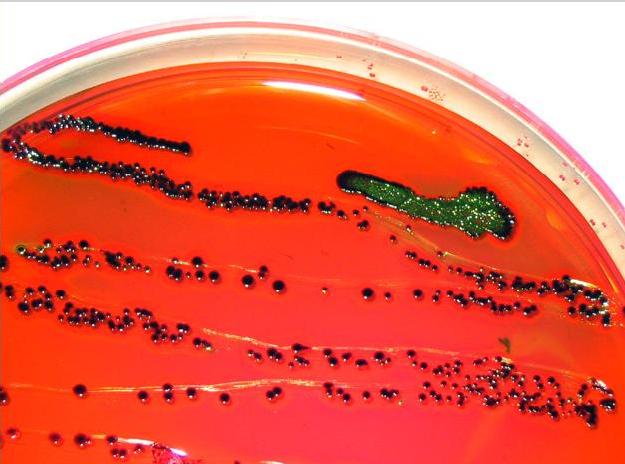

Az élelmiszerek és takarmányok sokfélesége miatt ez a horizontális módszer nem lehet minden részletében megfelelő bizonyos termékekre. E termékek esetén szükség lehet különböző, specifikus módszerek alkalmazására, ettől eltérni csak műszaki okokból lehetséges. Ugyanakkor ajánlott mindent elkövetni annak érdekében, hogy e horizontális módszert alkalmazzák.
2024. október 1-jén megjelent az MSZ ISO 4832:2023 Élelmiszerek és takarmányok mikrobiológiája. Horizontális módszer a koliformok megszámlálására. Telepszámlálásos módszer szabvány magyar nyelvű változata.
Az MSZ ISO 4832 általános irányelveket ad a koliformok megszámlálására. A szabványban leírt technika precíz, de nem teszi lehetővé, hogy mikrobiológiai vizsgálatot végezzenek nagy vizsgálati mintarészen. Ezért ez a preferált módszer, ha nagyszámú koliform van jelen. A szabvány alkalmazható:
- emberi fogyasztásra és állatok takarmányozására szánt élelmiszerekre; és
- környezeti mintákra az élelmiszer-előállítás és az élelmiszer-kezelés területén;
a telepek megszámlálásának technikája révén, szilárd tápközegen 30 °C-on vagy 37 °C-on történő inkubálás után.
A dokumentum a második kiadás (ISO 4832:1991) kismértékű átdolgozásával jött létre. Az előző kiadáshoz képest a főbb változások a következők:
- a 35 °C-on történő inkubálás alternatív eljárását törölék;
- a szabvány bővült a briliánszöld-laktóz-epe táplevesben végzett megerősítő vizsgálattal.
Tekintettel az előző kiadásához képest történt változások jellegére, az ISO 4832:1991-en alapuló alternatív módszerek validálását ez a felülvizsgálat nem érinti.
Szalay Anna
2024. október